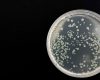

Months after withdrawal, brain activity during decision-making remained impaired in rats For the first time, researchers demonstrated in an animal how heavy alcohol use leads to long-term behavioral issues by damaging brain […]


Months after withdrawal, brain activity during decision-making remained impaired in rats For the first time, researchers demonstrated in an animal how heavy alcohol use leads to long-term behavioral issues by damaging brain […]

The advance makes it easier to detect circulating tumor DNA in blood samples, which could enable earlier cancer diagnosis and help guide treatment. Tumors constantly shed DNA from dying cells, which briefly […]

Researchers from the MRC Brain Network Dynamics Unit and Oxford University’s Department of Computer Science have set out a new principle to explain how the brain adjusts connections between neurons during learning. This new insight may […]

Stanford Medicine scientists describe details of the human intestine and placental tissue as part of the National Institute of Health’s Human Biomolecular Atlas Program. More often than not, studies of human biology […]

The pandemic is testing our societal structures like never before. To deal with it successfully, we need to think and act collectively, led by our key institutions. But at a time when […]

Most scientists agree that stringent control measures, involving efficient contact tracing, testing and isolation, together with social distancing and mask wearing, are required to limit the spread of SARS-CoV-2. South Korea, Taiwan, China and New Zealand have all […]

There are currently at least six COVID-19 vaccines in phase 3 clinical trials – the final phase of testing. These trials all aim to compare the safety and effectiveness of the vaccines […]

As anyone who’s ever mindlessly munched through an entire bag of chips can attest, it’s easy to keep eating once you start. Just putting something tasty in your mouth makes you want […]

Women are more likely than men to suffer adverse side effects of medications because drug dosages have historically been based on clinical trials conducted on men, suggests new research from UC Berkeley […]
The heroic efforts of researchers and healthcare professionals globally will eventually help us gain control of the coronavirus pandemic and there will be a decrease in the rate of new infections. The […]

Gordon Dougan is a Professor in the Department of Medicine, University of Cambridge, and has spent his career leading research into vaccines, pathogen genomics and disease tracking. His research work has helped […]

Scientists from the University of Oxford’s Engineering Science Department and the Oxford Suzhou Centre for Advanced Research (OSCAR) have developed a rapid testing technology for the novel corona virus SARS-CoV-2 (COVID-19). The […]

When it comes to managing anxiety disorders, William Shakespeare’s Macbeth had it right when he referred to sleep as the “balm of hurt minds.” While a full night of slumber stabilizes emotions, […]

Oxford University researchers have discovered that learnt knowledge is stored in different brain circuits depending on how we acquire it. The researchers from the Department of Experimental Psychology, the Wellcome Centre for […]